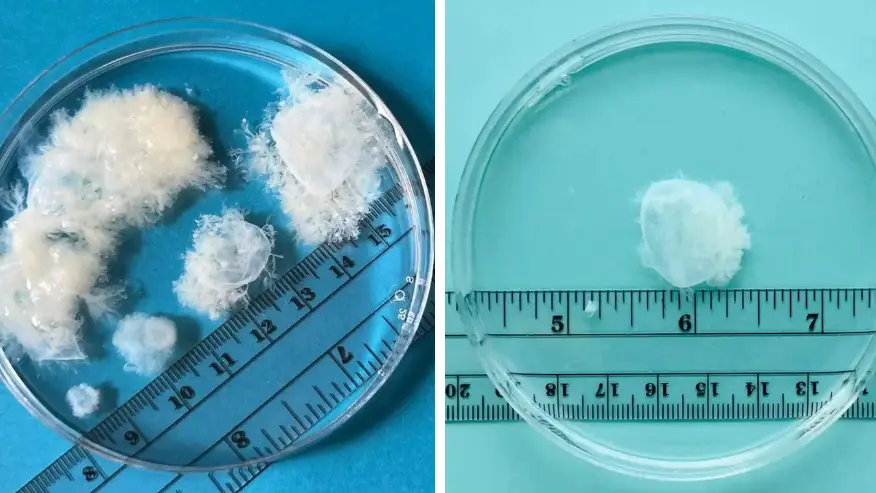
Woman shares what early abortions actually look like

*Warning: Contains images some may find upsetting.*
The topic of abortion has been hotly discussed following Roe V Wade's overturning, and now one doctor has revealed what early stage abortions actually look like.
When most of us think of pregnancy, we might imagine a small human in a person's womb from the get-go, but the reality is that early stage pregnancy does not resemble a human at all.
Advert
Instead, as shown in a series of pictures that went viral earlier this year, it looks like a small growth of cells that is white in appearance, not pink.
The images were shown as part of MYA Network's #IssueWithTissue project, with its co-founder Dr Joan Fleischman explaining that people are often 'stunned' when they see what early pregnancy actually looks like.
For many of them, she said they are 'relieved' and 'surprised' that their aborted pregnancies do not look like babies in their earliest states.
She continued: "That's when I realised how much the imagery on the internet and on placards - showing human-like qualities at this early stage of development - has really permeated the culture.
"People almost don't believe this is what comes out."

Dr Fleischman emphasised that these images are important to share as they directly contradict what is typically shown by pro-life protestors.
She mentioned, in particular, the six-week 'heartbeat' abortion ban which now exists in many states including Texas.
"Clinicians date pregnancy from the first day of your last period, to help predict the due date," she said. "But you're not pregnant for those first two weeks. So someone with a six-week pregnancy may have very little time after a missed period to get abortion care in states with a six-week limit."
The doctor stressed that images which depict an almost-human fetus at seven weeks are deceiving too, as they cause people to expect to 'see a little fetus with hands - a developed, miniature baby' when it actually looks nothing like this at all.
"A lot of early pregnancy images are driven by people who are against abortion and feel that life begins at conception, or by prenatal enthusiasts who want women to be excited about their pregnancy. What about people who aren't?" she said.

The images shared by the organisation caused a lot of shock when they were widely circulated online.
One TikTok user shared: "Her information is correct, I've been to multiple museums with human bio displays with the same stuff."
A second TikTok user added: "Thank you for spreading the info. People need to know the facts and not fear mongering propaganda!"
A third remarked of pro-life protestors: "They always use images (who knows if they're authentic or not) of late term fetuses when discussing 6 week bans. Education is so important."
However, not everyone was so approving of the images with some suggesting that they were fake, while others claimed that a visibly human fetus exists under the cells.
One wrote: "As an ultrasound tech of almost 20 years I can tell you that underneath some of that tissue would be a recognisable fetus. 6 wks is hard to tell [sic]."
A second claimed: "Well, that's fake."
For abortion support in the US, visit Planned Parenthood here. For abortion support in the UK and Northern Ireland, visit the NHS website here. For abortion support in Ireland, which has been lawful since March 2020, visit HSE here.